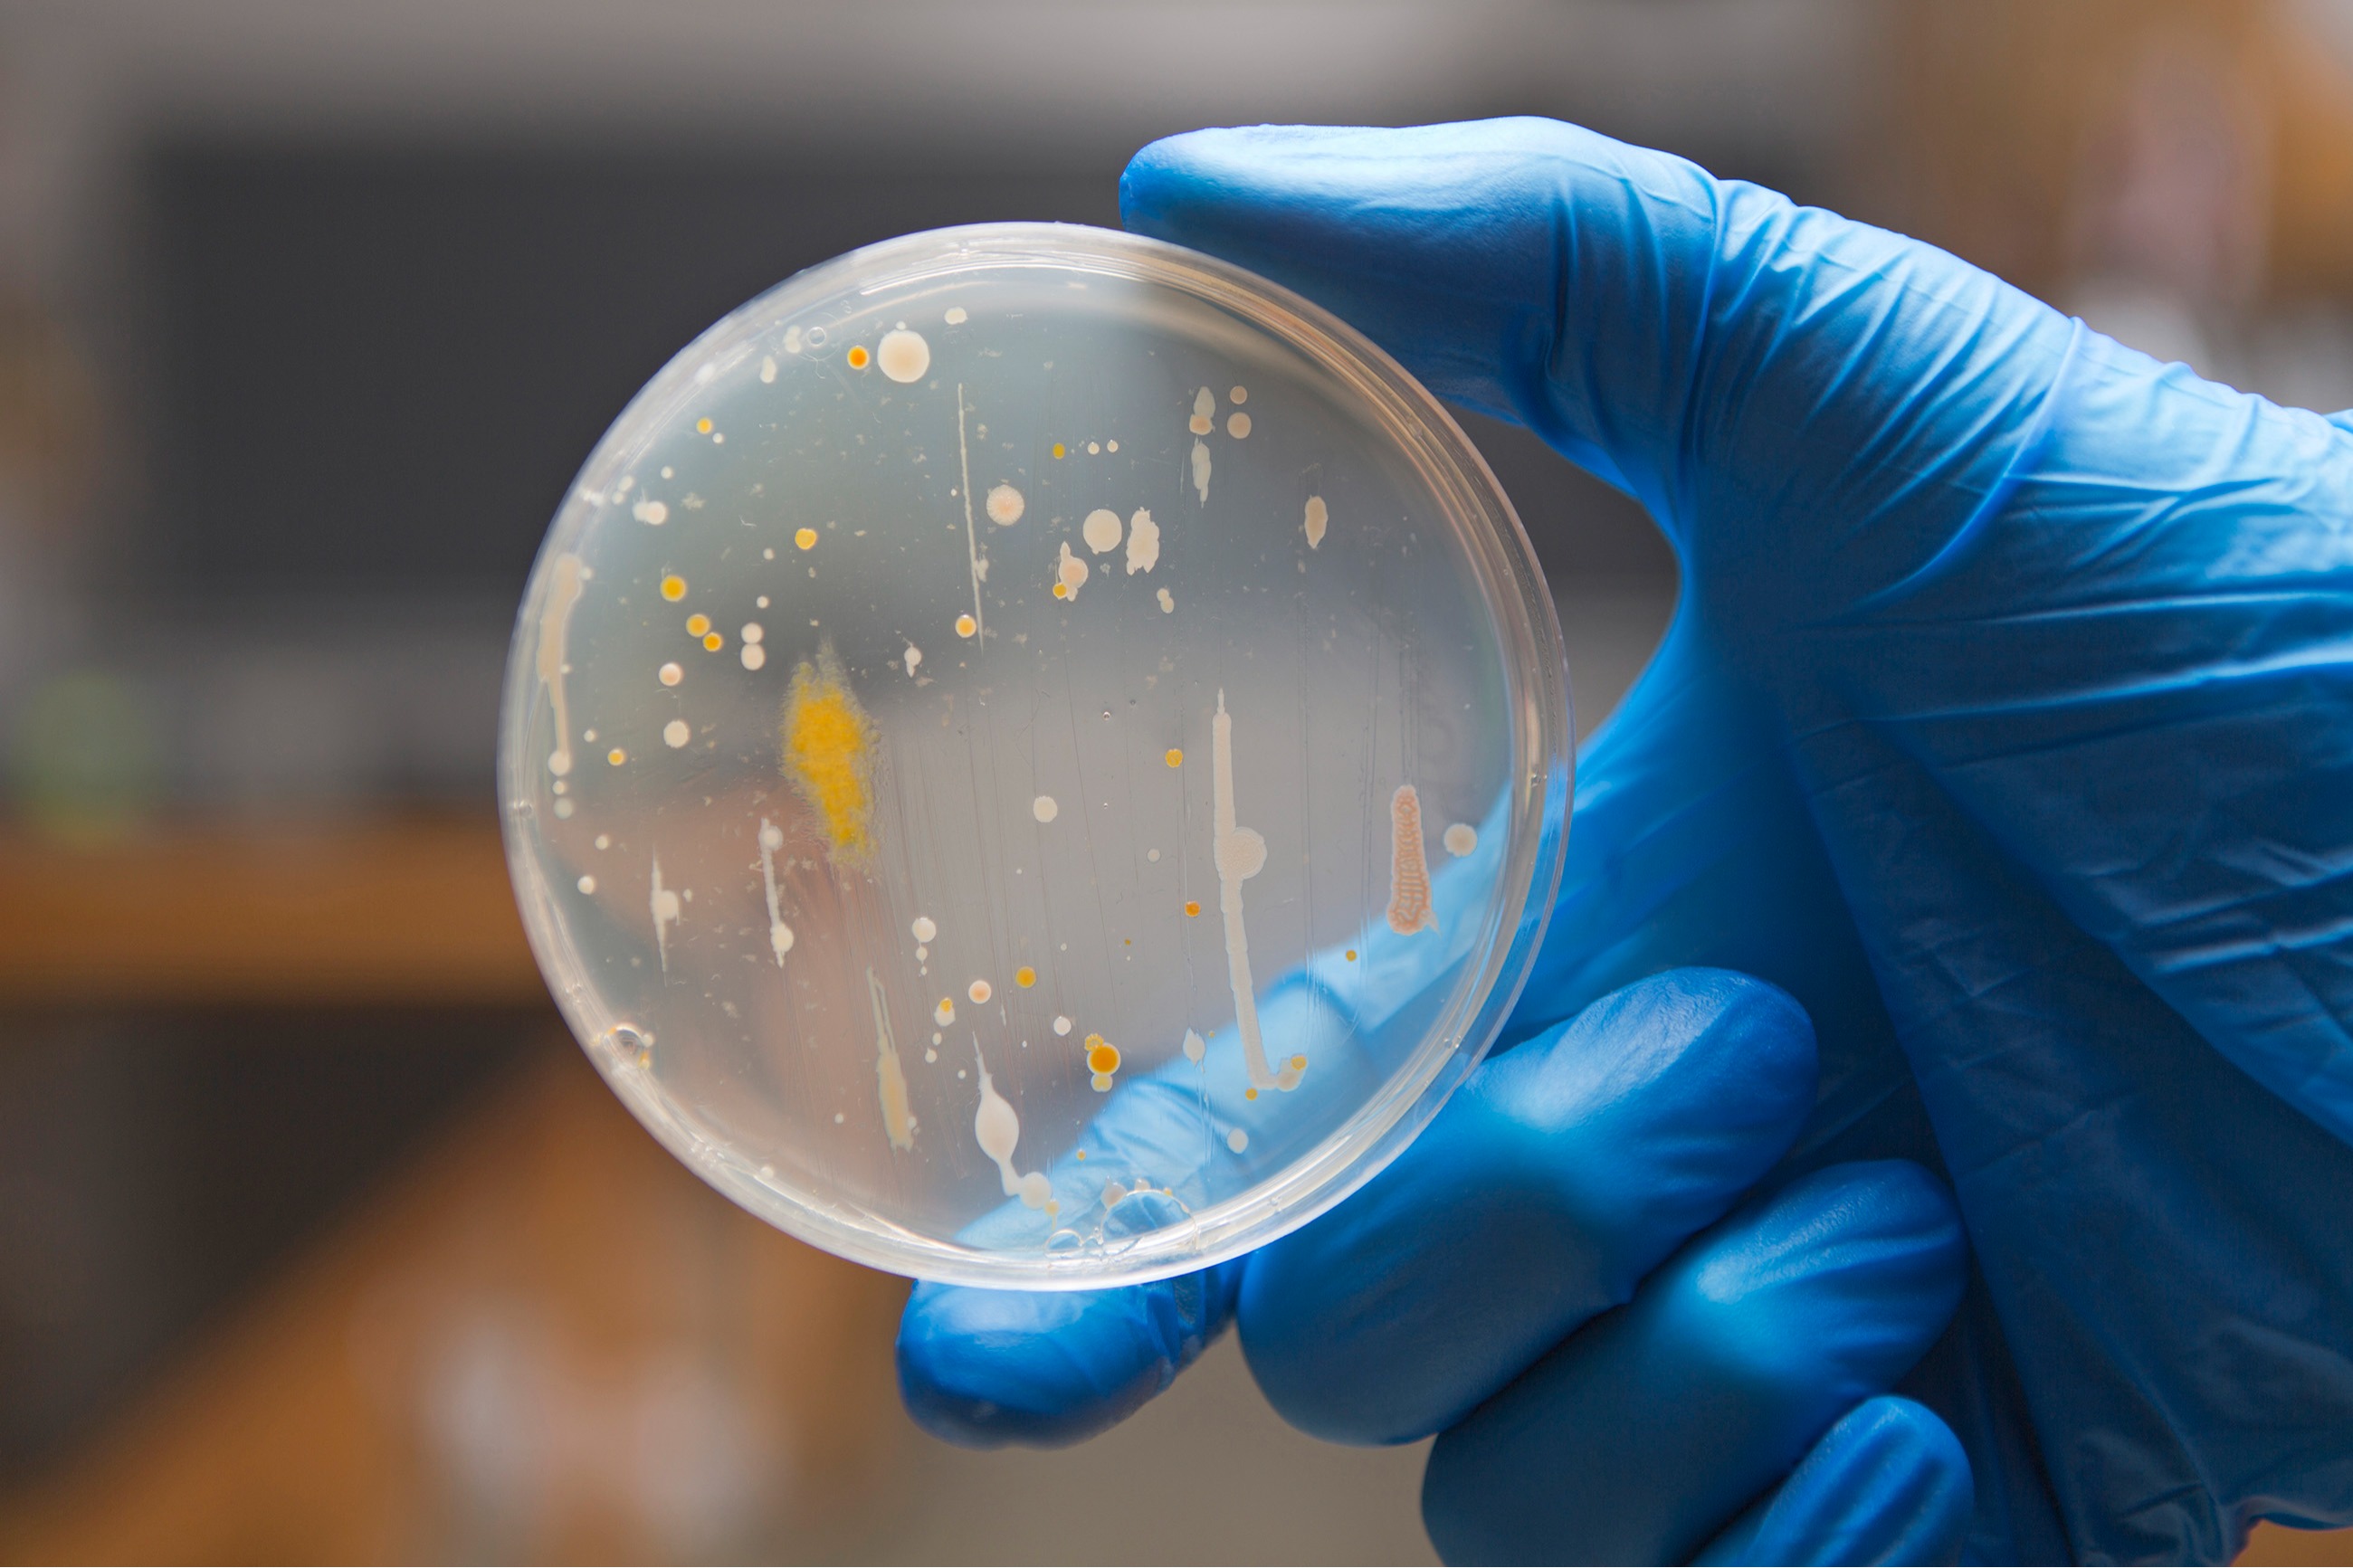

氨基酸感应机制与肿瘤治疗
2024-09-12A valuative criterion of K-polystability
2024-09-12
11月14日 高峰:长江与运河——苏轼的人生坐标
2024-09-12
Liver regeneration: roles of bile ducts and gallbladder
2024-09-11
以法之名:光影中的正义建构
2024-09-11
谈策展
2024-09-11
赵元任与国际中文教学
2024-09-11北极海冰多尺度物理过程:观测与认识
2024-09-11
何以归家:现代性的救赎
2024-09-10
Sample path properties and small ball probabilities for stochastic fractional diffusion equations
2024-09-10